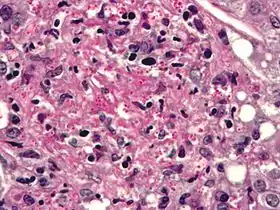

نوسجة مغمدة
النوسجة المغمدة (باللاتينية: Histoplasma capsulatum) هي فطر ينتمي لجنس النوسجات. تنتشر في أوهايو وحوض نهر الميسيسيبي. اكتشفها صامويل تايلور دارلنغ عام 1906.
مقالة مفصلة: نوسجة
اضغط هنا للاطلاع على كيفية قراءة التصنيف النوسجات | |
|---|---|
![]() | |
| المرتبة التصنيفية | نوع |
| التصنيف العلمي | |
| المملكة: | فطريات |
| الشعبة: | فطريات زقية |
| الشعيبة: | فنجانيانية |
| الطائفة: | عوفنيات |
| الرتبة: | Onygenales |
| الفصيلة: | أجيلوياتية |
| الجنس: | نوسجة صامويل تايلور دارلنغ، 1906 |
| الاسم العلمي | |
| Histoplasma capsulatum صموئيل تايلور دارلينغ ، 1906 | |
| الأنواع | |
| نوسجة مغمدة نوسجة دوبوازية | |
أسماء مرادفة
من الأسماء العلمية المرادفة:
- الكروانية السجقية (Coccidioides farciminosa)
- المستخفية الممحفظة (Cryptococcus capsulatus)
- المستخفية السجقية (Cryptococcus farciminosus)
- الفطريات الداخلية السجقية (Endomyces farciminosus)
- الغروبيلا السجقية (Grubyella farcinimosa)
- النوسجة المغمدة ضرب المغمدة (Histoplasma capsulatum var. capsulatum)
- النوسجة المغمدة ضرب السجقية (Histoplasma capsulatum var. farciminosum)
- النوسجة السجقية (Histoplasma farciminosum)
- Parendomyces farciminosus
- Posadasia capsulata
- السكيراء السجقية (Saccharomyces farciminosus)
- المتعجرة المتمحفظة (Torulopsis capsulata)
- المتعجرة السجقية (Torulopsis farciminosa)
- Zymonema farciminosum
معرض صور
طالع أيضا
مراجع
- Karimi, K; Wheat, LJ; Connolly, P; Cloud, G; Hajjeh, R; Wheat, E; Alves, K; Lacaz Cd Cda, S; Keath, E (1 December 2002). "Differences in histoplasmosis in patients with acquired immunodeficiency syndrome in the United States and Brazil". The Journal of Infectious Diseases. 186 (11): 1655–1660. doi:10.1086/345724. PMID 12447743. الوسيط
|CitationClass=تم تجاهله (مساعدة) - Rostocka, M; Hiltz, JE (1966). "Histoplasmin skin sensitivity in Nova Scotia". Canadian Journal of Public Health. 57 (9): 413–418. PMID 5981243. الوسيط
|CitationClass=تم تجاهله (مساعدة) - Leznoff, A; Frank, H; Telner, P; Rosensweig, J; Brandt, JL (1964). "Histoplasmosis in Montreal during the fall of 1963, with observations on erythema multiforme". Canadian Medical Association Journal. 91: 1154–1160. PMC 1928451. PMID 14226089. الوسيط
|CitationClass=تم تجاهله (مساعدة)
- بوابة علم الأحياء
- بوابة فطريات
نوسجة مغمدة في المشاريع الشقيقة
صور وملفات صوتية من كومنز
أنواع من ويكي أنواع.
This article is issued from Wikipedia. The text is licensed under Creative Commons - Attribution - Sharealike. Additional terms may apply for the media files.